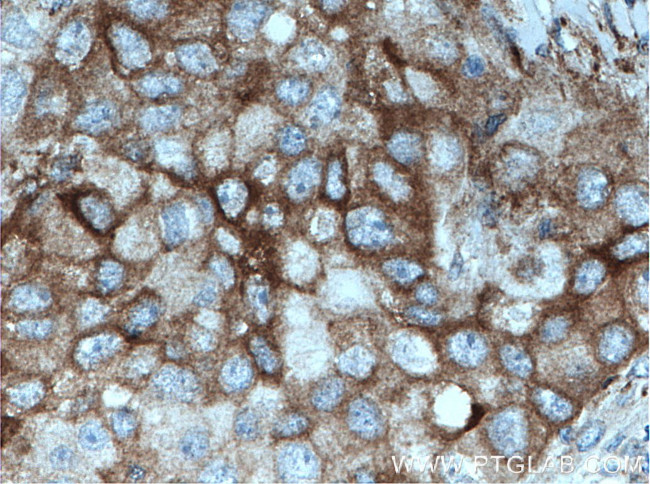
PKC Pan Antibody in Immunohistochemistry (Paraffin) (IHC (P))

Search
Proteintech
PKC Pan Polyclonal Antibody
{{$productOrderCtrl.translations['antibody.pdp.commerceCard.promotion.promotions']}}
{{$productOrderCtrl.translations['antibody.pdp.commerceCard.promotion.viewpromo']}}
{{$productOrderCtrl.translations['antibody.pdp.commerceCard.promotion.promocode']}}: {{promo.promoCode}} {{promo.promoTitle}} {{promo.promoDescription}}. {{$productOrderCtrl.translations['antibody.pdp.commerceCard.promotion.learnmore']}}
产品信息
12919-1-AP
种属反应
已发表种属
宿主/亚型
分类
类型
抗原
偶联物
形式
浓度
规格
纯化类型
保存液
内含物
保存条件
运输条件
产品详细信息
Immunogen sequence: FNFLMVLGK GSFGKVMLSE RKGTDELYAV KILKKDVVIQ DDDVECTMVE KRVLALPGKP PFLTQLHSCF QTMDRLYFVM EYVNGGDLMY HIQQVGRFKE PHAVFYAAEI AIGLFFLQSK GIIYRDLKLD NVMLDSEGHI KIADFGMCKE NIWDGVTTKT FCGTPDYIAP EIIAYQPYGK SVDWWAFGVL LYEMLAGQAP FEGEDEDELF QSIMEHNVAY PKSMSKEAVA ICKGLMTKHP GKRLGCGPEG ERDIKEHA (342-598 aa encoded by BC036472)
靶标信息
Members of the protein kinase C (PKC) family play a key regulatory role in a variety of cellular functions including cell growth and differentiation, gene expression, hormone secretion and membrane function. PKCs were originally identified as serine/threonine protein kinases whose activity was dependent on calcium and phospholipids. Diacylglycerols (DAG) and tumor promoting phorbol esters bind to and activate PKC. PKCs can be subdivided into at least two major classes including conventional (c) PKC isoforms ( alpha, betaI, betaII and gamma) and novel (n) PKC isoforms ( delta, epsilon, zeta, eta and theta). Patterns of expression for each PKC isoform differ among tissues and PKC family members exhibit clear differences in their cofactor dependencies. For instance, the kinase activities of nPKC delta and epsilon are independent of Ca2+.
仅用于科研。不用于诊断过程。未经明确授权不得转售。
生物信息学
蛋白别名: 14 - 3 - 3 - zeta isoform; AAG6; aging-associated gene 6; aPKC-lambda/iota; atypical protein kinase C; Atypical protein kinase C-lambda/iota; nPKC-delta; nPKC-epsilon; nPKC-eta; nPKC-iota; nPKC-theta; nPKC-zeta; PKC gamma; PKC theta; PKC zeta; PKC-A; PKC-alpha; PKC-B; PKC-beta; PKC-gamma; PKC-L; PKCdeltaVIII; PRKC-lambda/iota; Protein kinase C alpha type; protein kinase C alpha-polypeptide; protein kinase C beta I; protein kinase C beta II; Protein kinase C beta type; protein kinase C beta-II; Protein kinase C delta type; protein kinase C delta variant IX; protein kinase C delta VIII; Protein kinase C epsilon type; Protein kinase C eta type; Protein kinase C gamma type; Protein kinase C iota type; Protein kinase C theta type; protein kinase C type I (gamma type); protein kinase C zeta subspecies; Protein kinase C zeta type; protein kinase C, beta 1; protein kinase C, beta 1 polypeptide; protein kinase C, delta IV; protein kinase C, delta V; protein kinase C, lambda; protein kinase c-alpha; protein kinase C-eta; protein kinase C[d]; Protein uPEP2; Tyrosine-protein kinase PRKCD; unnamed protein product
基因别名: 14-3-3-zetaisoform; 2310021H13Rik; 5830406C15Rik; A130035A12Rik; A130082F03Rik; AAG6; AI098070; AI385711; AI427505; AI875142; ALPS3; aPKClambda; aPKCzeta; AW494342; C80388; CVID9; D14Ertd420e; DXS1179E; MAY1; mKIAA4165; nPKC-delta; nPKC-epsilon; nPKC-eta; nPKC-iota; nPKC-theta; nPKC-zeta; PKC; PKC-0; PKC-alpha; PKC-Beta; PKC-gamma; PKC-L; PKC-theta; PKC-ZETA; PKC2; PKC[d]; PKC[e]; PKCA; PKCalpha; PKCB; PKCbeta; PKCC; PKCD; PKCdelta; PKCE; Pkcea; PKCepsilon; PKCG; PKCgamma; Pkch; PKCI; PKCI(2); PKCI(3); PKCI+/-; PKCL; PKClambda; Pkcq; PKCtheta; Pkcz; PRKACA; Prkc; PRKCA; PRKCB; PRKCB1; PRKCB2; Prkcc; PRKCD; PRKCE; PRKCG; PRKCH; PRKCI; PRKCL; PRKCQ; PRKCT; PRKCZ; r14-3-3; R74924; R75156; RATPKCI; SCA14; uORF2; zetaPKC
UniProt ID: (Human) P17252, (Human) P05771, (Human) Q05655, (Human) Q02156, (Human) P05129, (Human) P24723, (Human) P41743, (Human) Q04759, (Human) Q05513, (Rat) P05696, (Mouse) P20444, (Mouse) F2Z441, (Rat) P68403, (Mouse) P28867, (Rat) P09215, (Mouse) P16054, (Rat) P09216, (Mouse) P63318, (Rat) P63319, (Mouse) P23298, (Rat) Q64617, (Mouse) Q62074, (Rat) F1M7Y5, (Mouse) Q02111, (Rat) P09217, (Mouse) Q02956
Entrez Gene ID: (Human) 5578, (Human) 5579, (Human) 5580, (Human) 5581, (Human) 5582, (Human) 5583, (Human) 5584, (Human) 5588, (Human) 5590, (Rat) 24680, (Mouse) 18750, (Mouse) 18751, (Rat) 25023, (Mouse) 18753, (Rat) 170538, (Mouse) 18754, (Rat) 29340, (Mouse) 18752, (Rat) 24681, (Mouse) 18755, (Rat) 81749, (Mouse) 18759, (Rat) 84006, (Rat) 85420, (Mouse) 18761, (Rat) 25522, (Mouse) 18762